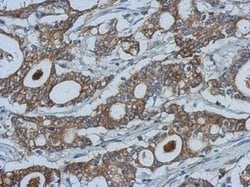
Invitrogen MMP10 Polyclonal Antibody 100 &mu;L; Unconjugated:Antibodies,

missing translation for 'onlineSavingsMsg'
Learn More
Learn More
Invitrogen™ MMP10 Polyclonal Antibody


Rabbit Polyclonal Antibody
Brand: Invitrogen™ PA529746
This item is not returnable.
View return policy
Description
Recommended positive controls: HepG2, human MMP10-transfected 293T, HepG2 conditioned medium. Predicted reactivity: Mouse (83%), Rat (80%). Store product as a concentrated solution. Centrifuge briefly prior to opening the vial.
MMP10 belongs to the matrix metalloproteinase family, and is generally secreted in its pro form, which is further modified by extracellular proteinases. As a metalloproteinase, MMP10 requires zinc and calcium as cofactors for activity. It is involved in the activation of pro-collagenase, catabolism of collagen, degradation of fibronectin, and tissue remodeling. In humans, the gene MMP10 located on chromosome 11.
Specifications
| MMP10 | |
| Polyclonal | |
| Unconjugated | |
| MMP10 | |
| AV377895; matrix metallo protease; matrix metallopeptidase 10; matrix metallopeptidase 10 (stromelysin 2); matrix metalloprotease 10; matrix metalloproteinase 10; matrix metalloproteinase 10 (stromelysin 2); matrix metalloproteinase-10; MMP; Mmp10; MMP-10; MMPs; SL-2; STMY2; stromelysin 2; stromelysin-2; Transformation-associated protein 34A; transin 2; transin-2 | |
| Rabbit | |
| Antigen affinity chromatography | |
| RUO | |
| 4319 | |
| Store at 4°C short term. For long term storage, store at -20°C, avoiding freeze/thaw cycles. | |
| Liquid |
| Immunohistochemistry (Paraffin), Western Blot | |
| 1 mg/mL | |
| 0.1M tris glycine with 20% glycerol and 0.01% thimerosal; pH 7 | |
| P09238 | |
| MMP10 | |
| Recombinant protein encompassing a sequence within the center region of human MMP10. The exact sequence is proprietary. | |
| 100 μL | |
| Primary | |
| Human | |
| Antibody | |
| IgG |
Product Content Correction
Your input is important to us. Please complete this form to provide feedback related to the content on this product.
Product Title
Spot an opportunity for improvement?Share a Content Correction